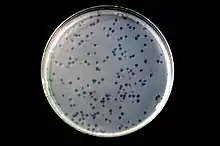

Sinorhizobium meliloti
Sinorhizobium meliloti are an aerobic, Gram-negative, and diazotrophic species of bacteria. S. meliloti are motile and possess a cluster of peritrichous flagella.[9] S. meliloti fix atmospheric nitrogen into ammonia for their legume symbionts, such as alfalfa. S. meliloti forms a symbiotic relationship with legumes from the genera Medicago, Melilotus and Trigonella, including the model legume Medicago truncatula. This symbiosis promotes the development of a plant organ, termed a root nodule. Because soil often contains a limited amount of nitrogen for plant use, the symbiotic relationship between S. meliloti and their legume hosts has agricultural applications, such as crop rotation.[10] These techniques reduce the need for inorganic nitrogenous fertilizers.[11]
| Sinorhizobium meliloti | |
|---|---|
 | |
| Sinorhizobium meliloti strain Rm1021 on an agar plate. | |
| Scientific classification | |
| Kingdom: | Bacteria |
| Phylum: | |
| Class: | |
| Order: | |
| Family: | |
| Genus: | |
| Species: | S. meliloti |
| Binomial name | |
| Sinorhizobium meliloti (Dangeard 1926) De Lajudie et al. 1994, comb. nov. | |
| Type strain | |
| ATCC 9930 CCUG 27879 | |
| biovars | |
| Synonyms | |
| |
Symbiosis

Symbiosis between S. meliloti and its legume hosts begins when the plant secretes an array of betaines and flavonoids into the rhizosphere: 4,4′-dihydroxy-2′-methoxychalcone,[12] chrysoeriol,[13] cynaroside,[13] 4′,7-dihydroxyflavone,[12] 6′′-O-malonylononin,[14] liquiritigenin,[12] luteolin,[15] 3′,5-dimethoxyluteolin,[13] 5-methoxyluteolin,[13] medicarpin,[14] stachydrine,[16] and trigonelline.[16] These compounds attract S. meliloti to the surface of the root hairs of the plant where the bacteria begin secreting nod factors. This initiates root hair curling. The rhizobia then penetrate the root hairs and proliferate to form an infection thread. Through the infection thread, the bacteria move toward the main root. The bacteria develop into bacteroids within newly formed root nodules and perform nitrogen fixation for the plant. A S. meliloti bacterium does not perform nitrogen fixation until it differentiates into a endosymbiotic bacteroid. A bacteroid depends on the plant for survival.[17]
Leghemoglobin, produced by leguminous plants after colonization of S. meliloti, interacts with the free oxygen in the root nodule where the rhizobia reside. Rhizobia are contained within symbiosomes in the root nodules of leguminous plants. The leghemoglobin reduces the amount of free oxygen present. Oxygen disrupts the function of the nitrogenase enzyme in the rhizobia, which is responsible for nitrogen fixation.[18]
Genome
The S. meliloti genome contains four genes coding for flagellin. These include fliC1C2–fliC3C4.[9] The genome contains three replicons: a chromosome (~3.7 megabases), a chromid (pSymB; ~1.7 megabases), and a plasmid (pSymA; ~1.4 megabases). Individual strains may possess additional, accessory plasmids. Five S. meliloti genomes have been sequenced to date: Rm1021,[19] AK83,[20] BL225C,[20] Rm41,[21] and SM11[22] with 1021 considered to be the wild type. Indeterminate nodule symbosis by S. meliloti is conferred by genes residing on pSymA.[23]
Bacteriophage
Several bacteriophages that infect Sinorhizobium meliloti have been described:[24] Φ1,[25] Φ1A,[26] Φ2A,[26] Φ3A,[27] Φ4 (=ΦNM8),[28] Φ5t (=ΦNM3),[28] Φ6 (=ΦNM4),[28] Φ7 (=ΦNM9),[28] Φ7a,[25] Φ9 (=ΦCM2),[28] Φ11 (=ΦCM9),[28] Φ12 (=ΦCM6),[28] Φ13,[29] Φ16,[29] Φ16-3,[30] Φ16a,[29] Φ16B,[27] Φ27,[25] Φ32,[30] Φ36,[30] Φ38,[30] Φ43,[25] Φ70,[25] Φ72,[30] Φ111,[30] Φ143,[30] Φ145,[30] Φ147,[30] Φ151,[30] Φ152,[30] Φ160,[30] Φ161,[30] Φ166,[30] Φ2011,[31] ΦA3,[25] ΦA8,[25] ΦA161,[31] ΦAL1,[32] ΦCM1,[31] ΦCM3,[31] ΦCM4,[31] ΦCM5,[31] ΦCM7,[31] ΦCM8,[31] ΦCM20,[31] ΦCM21,[31] ΦDF2,[32] Φf2D,[32] ΦF4,[33] ΦFAR,[32] ΦFM1,[31] ΦK1,[34] ΦL1,[29] ΦL3,[29] ΦL5,[29] ΦL7,[29] ΦL10,[29] ΦL20,[29] ΦL21,[29] ΦL29,[29] ΦL31,[29] ΦL32,[29] ΦL53,[29] ΦL54,[29] ΦL55,[29] ΦL56,[29] ΦL57,[29] ΦL60,[29] ΦL61,[29] ΦL62,[29] ΦLO0,[32] ΦLS5B,[31] ΦM1,[24][35] ΦM1,[24][36] ΦM1-5,[31] ΦM2,[37] ΦM3,[25] ΦM4,[25] ΦM5,[24][25] [38] ΦM5 (=ΦF20),[24][35] ΦM5N1,[31] ΦM6,[35] ΦM7,[35] ΦM8,[37] ΦM9,[35] ΦM10,[35] ΦM11,[35] ΦM11S,[31] ΦM12,[35][39] ΦM14,[35] ΦM14S,[31] ΦM19,[40] ΦM20S,[31][41] ΦM23S,[31] ΦM26S,[31] ΦM27S,[31] ΦMl,[42] ΦMM1C,[31] ΦMM1H,[31] ΦMP1,[43] ΦMP2,[43] ΦMP3,[43] ΦMP4,[43] ΦN2,[25] ΦN3,[25] ΦN4,[25] ΦN9,[25] ΦNM1,[31][41] ΦNM2,[31][41] ΦNM6,[31][41] ΦNM7,[31][41] ΦP6,[33] ΦP10,[33] ΦP33,[33] ΦP45,[33] ΦPBC5,[44] ΦRm108,[45] ΦRmp26,[46] ΦRmp36,[46] ΦRmp38,[46] ΦRmp46,[46] ΦRmp50,[46] ΦRmp52,[46] ΦRmp61,[46] ΦRmp64,[46] ΦRmp67,[46] ΦRmp79,[46] ΦRmp80,[46] ΦRmp85,[46] ΦRmp86,[46] ΦRmp88,[46] ΦRmp90,[46] ΦRmp145,[46] ΦSP,[25] ΦSSSS304,[47] ΦSSSS305,[47] ΦSSSS307,[47] ΦSSSS308,[47] and ΦT1.[25] Of these, ΦM5,[38] ΦM12,[39] Φ16-3[48] and ΦPBC5[44] have been sequenced.
As of March 2020 the International Committee on Taxonomy of Viruses (ICTV) has accepted the following species in its Master Species List 2019.v1 (#35):
- Realm: Duplodnaviria, Kingdom: Heunggongvirae, Phylum: Uroviricota
References
- Ba S, Willems A, de Lajudie P, Roche P, Jeder H, Quatrini P, Neyra M, Ferro M, Promé JC, Gillis M, Boivin-Masson C, Lorquin J (April 2002). "Symbiotic and taxonomic diversity of rhizobia isolated from Acacia tortilis subsp. raddiana in Africa". Systematic and Applied Microbiology. 25 (1): 130–45. doi:10.1078/0723-2020-00091. PMID 12086180.
- Maâtallah J, Berraho EB, Muñoz S, Sanjuan J, Lluch C (2002). "Phenotypic and molecular characterization of chickpea rhizobia isolated from different areas of Morocco". Journal of Applied Microbiology. 93 (4): 531–40. doi:10.1046/j.1365-2672.2002.01718.x. PMID 12234335. S2CID 598579.
- Rogel MA, Ormeño-Orrillo E, Martinez Romero E (April 2011). "Symbiovars in rhizobia reflect bacterial adaptation to legumes". Systematic and Applied Microbiology. 34 (2): 96–104. doi:10.1016/j.syapm.2010.11.015. PMID 21306854.
- León-Barrios M, Lorite MJ, Donate-Correa J, Sanjuán J (September 2009). "Ensifer meliloti bv. lancerottense establishes nitrogen-fixing symbiosis with Lotus endemic to the Canary Islands and shows distinctive symbiotic genotypes and host range". Systematic and Applied Microbiology. 32 (6): 413–20. doi:10.1016/j.syapm.2009.04.003. PMID 19477097.
- Villegas Mdel C, Rome S, Mauré L, Domergue O, Gardan L, Bailly X, Cleyet-Marel JC, Brunel B (November 2006). "Nitrogen-fixing sinorhizobia with Medicago laciniata constitute a novel biovar (bv. medicaginis) of S. meliloti". Systematic and Applied Microbiology. 29 (7): 526–38. doi:10.1016/j.syapm.2005.12.008. PMID 16413160.
- Mnasri B, Mrabet M, Laguerre G, Aouani ME, Mhamdi R (January 2007). "Salt-tolerant rhizobia isolated from a Tunisian oasis that are highly effective for symbiotic N2-fixation with Phaseolus vulgaris constitute a novel biovar (bv. mediterranense) of Sinorhizobium meliloti". Archives of Microbiology. 187 (1): 79–85. doi:10.1007/s00203-006-0173-x. PMID 17019605. S2CID 24133146.
- Gubry-Rangin C, Béna G, Cleyet-Marel JC, Brunel B (October 2013). "Definition and evolution of a new symbiovar, sv. rigiduloides, among Ensifer meliloti efficiently nodulating Medicago species". Systematic and Applied Microbiology. 36 (7): 490–6. doi:10.1016/j.syapm.2013.06.004. PMID 23871297.
- Bailly X, Olivieri I, Brunel B, Cleyet-Marel JC, Béna G (July 2007). "Horizontal gene transfer and homologous recombination drive the evolution of the nitrogen-fixing symbionts of Medicago species". Journal of Bacteriology. 189 (14): 5223–36. doi:10.1128/JB.00105-07. PMC 1951869. PMID 17496100.
- Aizawa, Shin-Ichi (2014-01-01). "Sinorhizobium meliloti — Nitrogen–Fixer in the Grassland". The Flagellar World. Academic Press. pp. 82–83. doi:10.1016/B978-0-12-417234-0.00026-8. ISBN 9780124172340.
- Adjei, M.B. (July 2006). "Nitrogen Fixation and Inoculation of Forage Legumes" (PDF). Uf/Ifas. Archived from the original (PDF) on 2016-12-02.
- Bederska-Błaszczyk, Magdalena; Sujkowska-Rybkowska, Marzena; Borucki, Wojciech (2021-01-04). "Sinorhizobium medicae 419 vs S. meliloti 1021: differences in root nodules induced by these two strains on the Medicago truncatula host". Acta Physiologiae Plantarum. 43 (1): 7. doi:10.1007/s11738-020-03166-1. ISSN 1861-1664. S2CID 230717774.
- Maxwell CA, Hartwig UA, Joseph CM, Phillips DA (November 1989). "A Chalcone and Two Related Flavonoids Released from Alfalfa Roots Induce nod Genes of Rhizobium meliloti". Plant Physiology. 91 (3): 842–7. doi:10.1104/pp.91.3.842. PMC 1062085. PMID 16667146.
- Hartwig UA, Maxwell CA, Joseph CM, Phillips DA (January 1990). "Chrysoeriol and Luteolin Released from Alfalfa Seeds Induce nod Genes in Rhizobium meliloti". Plant Physiology. 92 (1): 116–22. doi:10.1104/pp.92.1.116. PMC 1062256. PMID 16667231.
- Dakora FD, Joseph CM, Phillips DA (March 1993). "Alfalfa (Medicago sativa L.) Root Exudates Contain Isoflavonoids in the Presence of Rhizobium meliloti". Plant Physiology. 101 (3): 819–824. doi:10.1104/pp.101.3.819. PMC 158695. PMID 12231731.
- Peters NK, Frost JW, Long SR (August 1986). "A plant flavone, luteolin, induces expression of Rhizobium meliloti nodulation genes". Science. 233 (4767): 977–80. Bibcode:1986Sci...233..977P. doi:10.1126/science.3738520. PMID 3738520.
- Phillips DA, Joseph CM, Maxwell CA (August 1992). "Trigonelline and Stachydrine Released from Alfalfa Seeds Activate NodD2 Protein in Rhizobium meliloti". Plant Physiology. 99 (4): 1526–31. doi:10.1104/pp.99.4.1526. PMC 1080658. PMID 16669069.
- Oldroyd, Giles E.D.; Downie, J. Allan (June 2008). "Coordinating Nodule Morphogenesis with Rhizobial Infection in Legumes". Annual Review of Plant Biology. 59 (1): 519–546. doi:10.1146/annurev.arplant.59.032607.092839. ISSN 1543-5008. PMID 18444906.
- Nadler, Kenneth D.; Avissar, Yeal J. (1977-09-01). "Heme Synthesis in Soybean Root Nodules: I. On the Role of Bacteroid δ-Aminolevulinic Acid Synthase and δ-Aminolevulinic Acid Dehydrase in the Synthesis of the Heme of Leghemoglobin". Plant Physiology. 60 (3): 433–436. doi:10.1104/pp.60.3.433. ISSN 0032-0889. PMC 542631. PMID 16660108.
- Galibert F, Finan TM, Long SR, Puhler A, Abola P, Ampe F, et al. (July 2001). "The composite genome of the legume symbiont Sinorhizobium meliloti". Science. 293 (5530): 668–72. doi:10.1126/science.1060966. PMID 11474104. S2CID 18580010.
- Galardini M, Mengoni A, Brilli M, Pini F, Fioravanti A, Lucas S, et al. (May 2011). "Exploring the symbiotic pangenome of the nitrogen-fixing bacterium Sinorhizobium meliloti". BMC Genomics. 12: 235. doi:10.1186/1471-2164-12-235. PMC 3164228. PMID 21569405.
- The sequence hasn't been officially announced, but is available at NCBI: chromosome, pSymA, pSymB, and pRM41a.
- Schneiker-Bekel S, Wibberg D, Bekel T, Blom J, Linke B, Neuweger H, Stiens M, Vorhölter FJ, Weidner S, Goesmann A, Pühler A, Schlüter A (August 2011). "The complete genome sequence of the dominant Sinorhizobium meliloti field isolate SM11 extends the S. meliloti pan-genome". Journal of Biotechnology. 155 (1): 20–33. doi:10.1016/j.jbiotec.2010.12.018. PMID 21396969.
- DiCenzo, George; Wellappili, Deelaka; Brian Golding, G; Finan, Turlough (2018-03-21). "Inter-replicon Gene Flow Contributes to Transcriptional Integration in the Sinorhizobium meliloti Multipartite Genome". G3: Genes, Genomes, Genetics. 8 (5): 1711–1720. doi:10.1534/g3.117.300405. PMC 5940162. PMID 29563186.
- Systematic naming of bacteriophages is rarely followed in the scientific literature. Thus, a variety of phages end up sharing the same name. So, while there exists an RNA phage called ΦM12, which infects enterobacteria, it is not synonymous with the DNA phage ΦM12 listed here. The same may be true for other phages in this list. It should also be noted that within this list two phages have independently been named ΦM5.
- Lesley SM (1982). "A bacteriophage typing system for Rhizobium meliloti". Canadian Journal of Microbiology. 28 (2): 180–189. doi:10.1139/m82-024.
- Singh RB, Dhar B, Singh BD (1986). "Morphology and general characteristics of viruses active against cowpea Rhizobium CB756 and 32H1". Archives of Virology. 64 (1): 17–24. doi:10.1002/jobm.3620270309. PMID 7377972. S2CID 84732610.
- Handelsman J, Ugalde RA, Brill WJ (March 1984). "Rhizobium meliloti competitiveness and the alfalfa agglutinin". Journal of Bacteriology. 157 (3): 703–7. doi:10.1128/JB.157.3.703-707.1984. PMC 215314. PMID 6698937.
- Krsmanovi-Simic D, Werquin M (1977). "Etude des bactériophages de Rhizobium meliloti" [Study of bacteriophages of Rhizobium meliloti]. Comptes Rendus de l'Académie des Sciences, Série D (in French). 284: 1851–1854. and Krsmanovi-Simic D, Werquin M (1973). "Etude des bactériophages de Rhizobium meliloti" [Study of bacteriophages of Rhizobium meliloti]. Comptes Rendus de l'Académie des Sciences, Série D (in French). 276 (19): 2745–8. PMID 4198859.
- Kowalski M (1967). "Transduction in Rhizobium meliloti". Acta Microbiologica Polonica. 16 (1): 7–11. doi:10.1007/BF02661838. PMID 4166074. S2CID 10908418. Note that this article was reprinted in Plant and Soil (1971) 35 (1): 63—66, which is where the URL and doi direct to.
- Szende K, Ördögh F (1960). "Die Lysogenie von Rhizobium meliloti". Naturwissenschaften. 47 (17): 404–405. Bibcode:1960NW.....47..404S. doi:10.1007/BF00631269. S2CID 44438409.
The full genome of this phage is available at NCBI - Werquin M, Ackermann HW, Levesque RC (January 1988). "A Study of 33 Bacteriophages of Rhizobium meliloti". Applied and Environmental Microbiology. 54 (1): 188–196. doi:10.1128/AEM.54.1.188-196.1988. PMC 202420. PMID 16347525.
- Corral E, Montoya E, Olivares J (1978). "Sensitivity to phages in Rhizobium meliloti as a plasmid consequence". Microbios Letters. 5: 77–80.
- Kowalski M, Małek W, Czopska-Dolecka J, Szlachetka M (2004). "The effect of rhizobiophages on Sinorhizobium meliloti–Medicago sativa symbiosis". Biology and Fertility of Soils. 39 (4): 292–294. doi:10.1007/s00374-004-0721-y. S2CID 26352194.
- Wdowiak S, Małek W, Grzadka M (February 2000). "Morphology and general characteristics of phages specific for Astragalus cicer rhizobia". Current Microbiology. 40 (2): 110–3. doi:10.1007/s002849910021. PMID 10594224. S2CID 5181655.
- Finan TM, Hartweig E, LeMieux K, Bergman K, Walker GC, Signer ER (July 1984). "General transduction in Rhizobium meliloti". Journal of Bacteriology. 159 (1): 120–4. doi:10.1128/JB.159.1.120-124.1984. PMC 215601. PMID 6330024.
- Małek W (1990). "Properties of the transducing phage M1 of Rhizobium meliloti". Journal of Basic Microbiology. 30 (1): 43–50. doi:10.1002/jobm.3620300114. S2CID 86226063.
- Johansen E, Finan TM, Gefter ML, Signer ER (October 1984). "Monoclonal antibodies to Rhizobium meliloti and surface mutants insensitive to them". Journal of Bacteriology. 160 (1): 454–7. doi:10.1128/JB.160.1.454-457.1984. PMC 214744. PMID 6480561.
- Johnson MC, Sena-Veleza M, Washburn BK, Platta GN, Lua S, Brewer TE, Lynna JS, Stroupe ME, Jones KM (December 2017). "Structure, proteome and genome of Sinorhizobium meliloti phage ΦM5: A virus with LUZ24-like morphology and a highly mosaic genome". Journal of Structural Biology. 200 (3): 343–359. doi:10.1016/j.jsb.2017.08.005. PMID 28842338.
- Brewer Tess E, Elizabeth Stroupe M, Jones Kathryn M (Dec 25, 2013). "The genome, proteome and phylogenetic analysis of Sinorhizobium meliloti phage ΦM12, the founder of a new group of T4-superfamily phages". Virology. 450–451: 84–97. doi:10.1016/j.virol.2013.11.027. PMID 24503070.
- Campbell GR, Reuhs BL, Walker GC (October 1998). "Different phenotypic classes of Sinorhizobium meliloti mutants defective in synthesis of K antigen". Journal of Bacteriology. 180 (20): 5432–6. doi:10.1128/JB.180.20.5432-5436.1998. PMC 107593. PMID 9765576.
- Werquin M, Ackermann HW, Levesque RC (1989). "Characteristics and comparative study of five Rhizobium meliloti bacteriophages". Current Microbiol. 18 (5): 307–311. doi:10.1007/BF01575946. S2CID 11937563.
- Małek W (1990). "Properties of the transducing phage Ml of Rhizobium meliloti". Journal of Basic Microbiology. 30 (1): 43–50. doi:10.1002/jobm.3620300114. S2CID 86226063. Archived from the original on 2013-01-05.
- Martin MO, Long SR (July 1984). "Generalized transduction in Rhizobium meliloti". Journal of Bacteriology. 159 (1): 125–9. doi:10.1128/JB.159.1.125-129.1984. PMC 215602. PMID 6330025.
- This phage has never been formally reported in the scientific literature. However, the full genomic sequence has been uploaded to NCBI, available here.
- Novikova NI, Bazenova OV, Simarov BV (1987). "Phage sensitivity of natural and mutant strains of alfalfa nodule bacteria differing by cultural and symbiotic properties. (Summary in English)". Agric. Biol. 2: 35–39.
- Khanuja SP, Kumar S (1989). "Symbiotic and galactose utilization properties of phage RMP64-resistant mutants affecting three complementation groups in Rhizobium meliloti". Journal of Genetics. 68 (2): 93–108. doi:10.1007/BF02927852. S2CID 25258531.
- Sharma RS, Mishra V, Mohmmed A, Babu CR (April 2008). "Phage specificity and lipopolysaccarides of stem- and root-nodulating bacteria (Azorhizobium caulinodans, Sinorhizobium spp., and Rhizobium spp.) of Sesbania spp". Archives of Microbiology. 189 (4): 411–8. doi:10.1007/s00203-007-0322-x. PMID 17989956. S2CID 5746480.
- Φ16-3 Complete Genome
Further reading
- Chi F, Shen SH, Cheng HP, Jing YX, Yanni YG, Dazzo FB (November 2005). "Ascending migration of endophytic rhizobia, from roots to leaves, inside rice plants and assessment of benefits to rice growth physiology". Applied and Environmental Microbiology. 71 (11): 7271–8. doi:10.1128/AEM.71.11.7271-7278.2005. PMC 1287620. PMID 16269768.
- Chi F, Yang P, Han F, Jing Y, Shen S (May 2010). "Proteomic analysis of rice seedlings infected by Sinorhizobium meliloti 1021". Proteomics. 10 (9): 1861–74. doi:10.1002/pmic.200900694. PMID 20213677. S2CID 22652087.